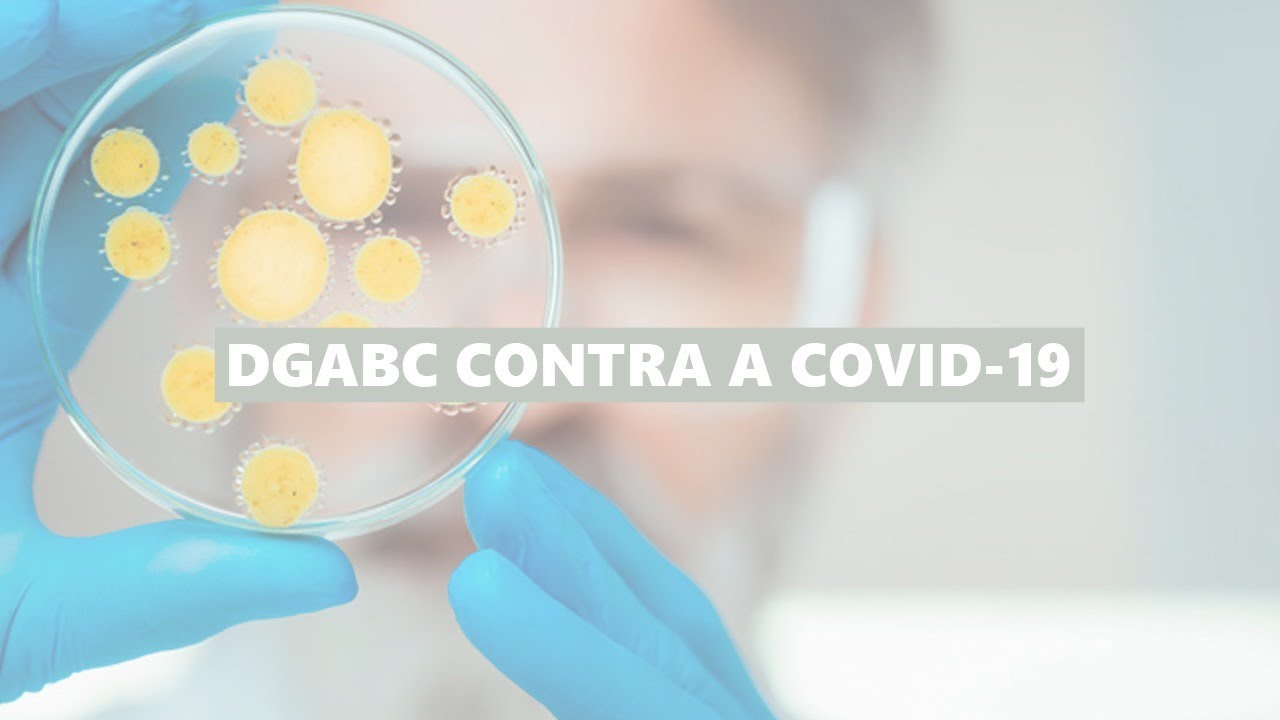
Boletim - Coronavírus (155)

Projeto Ecovias, a Vida Passa por Aqui - Diversidade
Jacqueline Moura, coordenadora de recursos humanos da Ecovias, fala sobre o tema Diversidade, que a empresa vem tratando com cada vez mais interesse, capacitando pessoas, criando oportunidades de trabalho e conscientizando os próprios funcionários, entre outras ações inclusivas e de equidade.




 Santo André 15° C
Santo André 15° C
 Rio Grande da Serra 15° C
Rio Grande da Serra 15° C